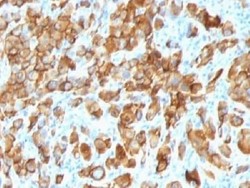

Antibody data
- Antibody Data
- Antigen structure
- References [0]
- Comments [0]
- Validations
- Immunohistochemistry [3]
Submit
Validation data
Reference
Comment
Report error
- Product number
- NBP2-34786-0.1 mg - Provider product page

- Provider
- Novus Biologicals
- Product name
- Mouse Monoclonal Melan-A/MART-1 Antibody
- Antibody type
- Monoclonal
- Description
- Protein A purified. This antibody recognizes a protein doublet of 20-22kDa, identified as MART-1 (Melanoma Antigen Recognized by T cells 1) or Melan-A. MART-1 is a newly identified melanocyte differentiation antigen recognized by autologous cytotoxic T lymphocytes. Seven other melanoma associated antigens recognized by autologous cytotoxic T cells include MAGE-1, MAGE-3, tyrosinase, gp100, gp75, BAGE-1, and GAGE-1. Subcellular fractionation shows that MART-1 is present in melanosomes and endoplasmic reticulum. This MAb labels melanomas and other tumors showing melanocytic differentiation. It is also a useful positive-marker for angiomyolipomas. It does not stain tumor cells of epithelial, lymphoid, glial, or mesenchymal origin.
- Reactivity
- Human, Mouse, Rat
- Host
- Mouse
- Isotype
- IgG
- Vial size
- 0.1 mg
- Concentration
- 1.0 mg/ml
- Storage
- Store at 4C short term. Aliquot and store at -20C long term. Avoid freeze-thaw cycles.
No comments: Submit comment
Supportive validation
- Submitted by
- Novus Biologicals (provider)
- Main image

- Experimental details
- Immunohistochemistry-Paraffin: Melan-A/MART-1 Antibody (SPM540) - Azide and BSA Free [NBP2-34786] - Formalin-paraffin human melanoma stained with Melan-A MAb (SPM540). Note cytoplasmic staining of cells.
- Submitted by
- Novus Biologicals (provider)
- Main image

- Experimental details
- Immunohistochemistry-Paraffin: Melan-A/MART-1 Antibody (SPM540) - Azide and BSA Free [NBP2-34786] - Formalin-paraffin human melanoma stained with Melan-A MAb (SPM540). Note cytoplasmic staining of cells.
- Submitted by
- Novus Biologicals (provider)
- Main image
- Experimental details
- Immunohistochemistry-Paraffin: Melan-A/MART-1 Antibody (SPM540) - Azide and BSA Free [NBP2-34786] - Formalin-paraffin human melanoma stained with Melan-A MAb (SPM540). Note cytoplasmic staining of cells.
 Explore
Explore Validate
Validate Learn
Learn Western blot
Western blot Immunohistochemistry
Immunohistochemistry